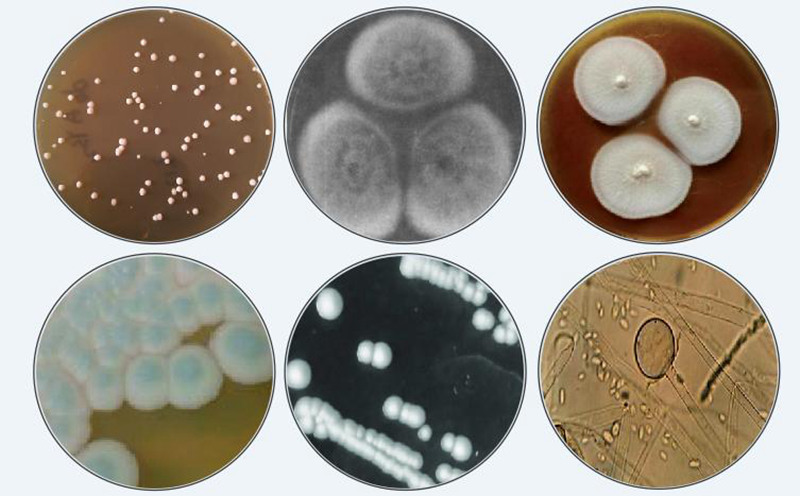
图片8.jpg

中经总网/世界品牌研究院讯(王启明 樊晔)汾酒,这一见证了五千年中华文明的传统名酒,融合了悠久的历史与匠心独运的酿造技艺。它的独特风味,离不开微生物的默默奉献。在汾酒冬酿中,这些“精灵”更是赋予了汾酒清香品质独特的灵魂和生命力。
随着冬季的悄然到来,山西杏花村的气温下降,空气中弥漫着清冷,但汾酒微生物酿酒军团却如火如荼地展开着一场酿造盛宴。首当其冲的是酿酒军团的先锋队——霉菌,它们主要负责将高粱中的淀粉分解转化为可以发酵利用的单糖,代表成员来自横梗霉属、红曲属、根霉属、毛霉属等。紧接其后的是酒精发酵的核心角色——酵母菌,它们将单糖转化为酒精,为汾酒风味的形成奠定基础,代表成员来自酵母属、克鲁维酵母属、汉逊酵母属。最后是汾酒风味的驱动者与缔造者——生香微生物,它们利用各种营养物质,生成酯、酸、醇、醛等多种复杂的香味成分,最终成就了汾酒卓越的清香品质,代表成员来自毕赤氏酵母属、乳酸杆菌属、醋酸杆菌属、芽孢杆菌属等。
在冬季,酿酒师可以更精确地控制温度和湿度,确保微生物在理想的环境下发挥最佳效果,从而使酒醅的发酵过程更加均匀稳定、缓慢而充分。研究表明,冬酿汾酒具有不可比拟的微生物群落结构,其中扣囊复膜酵母、酿酒酵母和耐酸乳杆菌等关键功能微生物的活跃期和数量明显提升,不仅提高了出酒率,同时有助于汾酒“清香纯正、余味爽净”风格特征的稳定与提升。同时,低温环境有效抑制有害微生物的生长,却为有益微生物提供了理想的生长和繁殖条件。这些有益微生物数目种类众多,通过参与发酵生成各种香气成分。香气与味道经过低温酿造,相互协调融合,为汾酒增添了独特的层次感。正如诗人苏辙描述的:“井底屠酥浸旧方,床头冬酿压琼浆”,可见冬酿美酒的弥足珍贵。

2024“汾酒试点”,汾酒将继续守正创新,坚持“酿好酒、储老酒、售美酒”的品质纲领,围绕“41999”的遗产模式、赋能模式、经营管理模式、前瞻性研究四大模式开展一系列的工艺品质科研工作,让传统的更传统,让现代的更现代,努力为广大消费者提供更高品质的产品和更好的消费体验。

中经总网·中经在线
世界品牌研究院
世界品牌研究(工作)办公室
(备案编码:11010910200873)
联合报道
发布:中经总网·中经在线
总编审:王海珠
总监制:熊辉
编辑:郑建华 刘信春
中经总网·中经在线北京媒体团-全媒体宣传矩阵(重点合作支持报道):中经总网、中经在线、《祖国》杂志-祖国网、《中国企业报》、《企业家》杂志、《中国化妆品》杂志、人民政协网、中国日报网、中国网、中华网、中国报道网、中外新闻社-中外新闻网、《灿烂中国》全媒体、中国品牌经济网、中国应急安全网、中法新闻法制网、华人头条、今日头条、顶端新闻、正观新闻、封面新闻、百度百家、凯迪财经、雪球财经、凤凰、腾讯、搜狐、网易、优酷、爱奇艺、知乎、东方财富网等近百家网络媒体平台。整合传统媒体、网络媒体、移动互联媒体资源,构建全媒体宣传矩阵平台,更好地服务于地方经济高质量发展,服务于中国企业品牌转型升级。(旗下拥有商标:中经总®网、中经三驾马车®;及版权:中经总网©、中城环球©、中经智谷©、世界品牌研究院©、世界品牌©、世界品牌智库©、世界品牌盛典©、世界品牌之夜©、向世界推介·中国品牌©等多项国家知识产权保护。)


■ 中经总网【内部简报】-组织专家企业家考察团走进企业交流合作
■ 合作推介| 联合国旅游组织专家团队-德安杰环球顾问集团简介
【免责声明】:转载自其他平台或媒体的文章,本平台将注明来源及作者,但不对所包含内容的准确性、可靠性或完整性提供任何明示或暗示的保证,仅作参考。《©中经总网》只用于学习、欣赏、不用于任何商业盈利、如有侵权,请联系本平台并提供相关书页证明,本平台将更正来源及作者或依据著作权人意见删除该文,并不承担其他任何责任。





















